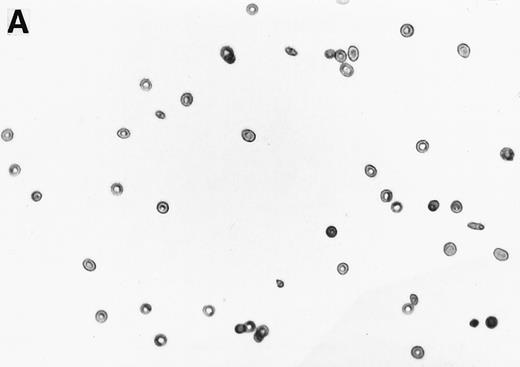

Abstract
We show that N-acetylcysteine (NAC) has the ability to cause statistically significant diminishment in the in vitro formation of irreversibly sickled cells (ISCs) at concentrations greater than 250 μmol/L. Other antioxidants, approved for human use (cysteamine, succimer, dimercaprol), were not efficacious. NAC had the ability to cause statistically significant conversion of ISCs formed in vivo back to the biconcave shape. NAC was also shown to reduce the formation of dense cells and increase the available thiols in β-actin. We showed that diminishing reduced glutathione (GSH), by treatment with 1-chloro-2,4-dinitrobenzene, resulted in increased dense cells. We conclude the NAC blocks dense cell formation and ISC formation by targeting channels involved in cellular dehydration and β-actin, respectively. The efficacy of NAC is probably due to its combined antioxidant activity and ability to increase intracellular GSH.
BLOOD FROM HOMOZYGOUS sickle cell (SS) patients can be separated by density gradient sedimentation into morphologically and physiologically distinct red blood cell (RBC) classes.1 The highest density class of RBCs includes irreversibly sickled cells (ISCs) (60% to 85%) that retain a sickled shape in well-oxygenated blood where the sickle cell hemoglobin (HbS) is depolymerized. These ISCs represent up to 45% of the circulating RBCs in SS blood and they are poorly deformable, of short life span, and have lower levels of fetal hemoglobin than do reversibly sickled cells (RSCs).2 During the course of vasoocclusion, the highest density class of SS RBCs is selectively trapped in the microvasculature.3,4 The dense cell population appears to block the narrowed lumen of vessels lined primarily with the more adherent lower density RBCs.5 Hemolysis is correlated with the dense cell population, which contains RBCs that have the greatest propensity to form polymer, are most susceptible to shear stress, and appear to play an essential role in vasoocclusion.6-8
The spectrin membrane skeleton controls the shape, elasticity, and flexibility of the RBC.9 The major essential components of the membrane skeleton are spectrin, protein 4.1, and actin.10 We have recently shown that a posttranslational modification in ISC β-actin, in which a disulfide bridge forms between cysteine 284 and cysteine 373,11,12 leads to an ISC membrane skeleton, which can only slowly disassemble at 37°C.11,13 The slow disassembly is caused by altered ISC actin polymerization-depolymerization kinetics.14 Based on this evidence, we proposed that the inability of ISC membrane skeletal proteins to reassemble at 37°C leads to the ISC skeleton's inability to remodel.15 Furthermore, we proposed that membrane permeable reducing agents or antioxidants, which can block the β-actin disulfide bridge from forming, should be able to inhibit ISC formation.15
Jensen et al16 found that ISCs could be generated in vitro when SS RBCs were kept under deoxygenation conditions for 24 hours. Based on this finding, Ohnishi et al17 showed that ISCs can be efficiently generated in vitro by deoxygenation-reoxygenation cycling of RSCs. We have made use of the methodology to test the efficacy of various clinically relevant reducing agents or antioxidants to block ISC formation in vitro. In this study, we show that (1) N-acetylcysteine has the ability to block ISC formation at pharmacologically achievable dosages; (2) N-acetylcysteine can convert a portion of ISCs formed in vivo back to biconcave cells; (3) the inhibition of ISC formation in vitro is due, in part, to N-acetylcysteine's ability to block dense cell formation; and (4) diminution of reduced glutathione (GSH) levels in light density SS erythrocytes is sufficient to cause dense cell formation. We conclude that N-acetylcysteine's efficacy in reducing ISC formation is due to its combined antioxidant activity and ability to increase intracellular reduced GSH levels.
MATERIALS AND METHODS
Preparation of light density and high density SS RBCs.
The methodology used to separate light density and high density SS RBCs is based on Shartava et al.11 Blood (20 to 30 mL) was obtained by venipuncture from homozygous SS subjects in vacutainer tubes containing 143 USP units of lithium heparin. Fresh blood (5 mL/gradient) was placed over a discontinuous Percoll density gradient containing 7 mL each of 45%, 50%, 55%, 60%, and 65% Percoll in 18% Renografin M-60 (Squibb Diagnostics, Princeton, NJ) in 20 mmol/L HEPES, 10 mmol/L MgCl2, 10 mmol/L glucose, pH 7.4. The blood was sedimented at 907g for 45 minutes at 4°C and the light density cells (45% layer) were removed without cross contamination. The low density cells were washed two times in phosphate-buffered saline (PBS) (10 mmol/L NaPO4, 150 mmol/L NaCl, pH 7.6) and sedimented at 2,520g for 5 minutes. A 2% suspension of low density cells was prepared in incubation buffer (20 mmol/L HEPES, pH 7.4, 130 mmol/L NaCl, 5 mmol/L KCl, 1 mmol/L MgCl2, 1 mmol/L glucose, 2 mmol/L NaPO4, 2 mmol/L CaCl2, 1 mmol/L adenosine, 0.5% bovine serum albumin [BSA] and 100 U/mL penicillin G, 100 μg/mL streptomycin, 0.25 μg/mL Amphotericin B).
In vitro formation of ISCs by cyclic oxygenation-deoxygenation and inhibition by reducing agents and antioxidants.
The 2% solution of light density cells in 10 mL of incubation buffer plus varying concentrations of reducing agents or antioxidants was placed in 50 mL volumetric flasks. The samples were incubated at 37°C, in a shaker water bath, with cycling of 15 minutes N2 followed by 5 minutes air for a total time of 16 hours. After 16 hours, the samples were flushed with O2 for 20 minutes, and aliquots were fixed with 1% glutaraldehyde. Blood smears were prepared and a minimum of 500 RBCs counted to determine percent ISCs. Cells with a length/width ratio of ≥ 2 were counted as ISCs. As can be seen in Fig 1, cells with multiple projections were rarely encountered. When they were encountered, they were not counted as ISCs. In some experiments, cyclic oxygenation-deoxygenation was followed by density separation as described above. In these experiments, each layer of the gradient containing RBCs was washed twice with PBS and the number of RBCs was counted using the Cell Dyn (Sequoia-Turner, Mountain View, CA).
Generation of ISCs after in vitro cycling. (A) Shows light density RBCs before in vitro cycling. (B) Shows SS erythrocytes after 16 hours of in vitro cycling in the absence of NAC. (C) Shows SS erythrocytes cycled in the presence of 20 mmol/L NAC with a reduction in the formation of ISCs.
Generation of ISCs after in vitro cycling. (A) Shows light density RBCs before in vitro cycling. (B) Shows SS erythrocytes after 16 hours of in vitro cycling in the absence of NAC. (C) Shows SS erythrocytes cycled in the presence of 20 mmol/L NAC with a reduction in the formation of ISCs.
Determination of β-actin thiols after cyclic oxygenation-deoxygenation.
For those experiments in which we measured β-actin thiols, we began the cyclic oxygenation-deoxygenation with a 2% solution of light density cells in 300 mL of incubation buffer. At the end of the 16-hour cycling, we washed the cells three times with PBS (sedimenting at 2,520g for 5 minutes), isolated ghosts, membrane skeletons, and β-actin according to Shartava et al.11 Thiols were measured on β-actin samples using 5,5′-dithiobis-(2-nitrobenzoate) (DTNB).11
Reduction of intracellular GSH using 1-chloro-2,4-dinitrobenzene (CDNB).
Low density sickle cells (LDSS) were treated with 1 mmol/L chloro-dinitrobenzene (CDNB) in incubation buffer at 4°C for varying times as described in the text. Controls were kept in the same conditions minus CDNB. Incubated LDSS erythrocytes were separated in Percoll density gradients as described above and GSH per RBC was measured as follows. RBCs from the Percoll layers were washed with PBS. Packed RBCs were placed in 25 vol of dH2O for 5 minutes at 22°C. Sufficient 100% trichloro-acetic acid (TCA) was added to bring the final concentration to 10% TCA, and the mixture was kept on ice for 5 minutes. Precipitate was sedimented (10,000g, 5 minutes). One volume of the supernatant was mixed with 4 vol of 0.5 mol/L Tris pH 8.2. A final concentration of 0.2 mmol/L DTNB (from a 10 mmol/L stock solution in 1% NaHCO3) was added to the sample and incubated for 30 minutes. After incubation, DTNB absorbance was read at 412 nm. Molar concentration of GSH was calculated based on an extinction coefficient E = 13,600 M−1 · cm−1.
Conversion of de novo ISCs to the biconcave shape.
High density SS erythrocytes were isolated, from fresh blood, from the 65% Percoll layer upon density separation. The high density SS erythrocytes were washed three times with PBS and then were brought to a 2% solution in incubation buffer. The incubation, in the presence of varying concentrations of N-acetylcysteine (NAC), was performed at 37°C for 16 hours with shaking. At the end of 16 hours, the cells were fixed with glutaraldehyde, blood smears prepared, and ISCs counted.
Statistical analysis.
Using one-way and two-way analysis of variance (ANOVA), we first tested for significant differences among the means observed for varying concentrations of NAC (or dithiothreitol [DTT]). Once the difference was found to be significant, multiple comparisons using Dunnett's test (for comparing treatments with control) were performed. The P values were derived through the use of Dunnett's test.
RESULTS
We first tested the efficacy of a small membrane permeable reducing agent, DTT, to block the formation of ISCs in vitro (Table 1). We found that DTT caused statistically significant decreases in the number of ISCs formed at all concentrations tested from 1.0 mmol/L to 5.0 mmol/L. At 5.0 mmol/L, we obtained a reduction of 30.3% in the number of ISCs (Table 1). Higher concentrations of DTT caused clustering of RBCs.
Effect of DTT on ISC Formation In Vitro
| [DTT] . | Time (h) . | % ISCs . | Δ ISCs . |
|---|---|---|---|
| 0 mmol/L | 0 | 8.3 ± 3.5 (4) | |
| 0 mmol/L | 16 | 42.6 ± 3.5 (4) | |
| 1.0 mmol/L | 16 | 32.2 ± 0.9 (4)-150 | −24.4%-150 |
| 2.5 mmol/L | 16 | 30.7 ± 2.5 (4)-150 | −27.9%-150 |
| 5.0 mmol/L | 16 | 29.7 ± 4.8 (4)-150 | −30.3%-150 |
| [DTT] . | Time (h) . | % ISCs . | Δ ISCs . |
|---|---|---|---|
| 0 mmol/L | 0 | 8.3 ± 3.5 (4) | |
| 0 mmol/L | 16 | 42.6 ± 3.5 (4) | |
| 1.0 mmol/L | 16 | 32.2 ± 0.9 (4)-150 | −24.4%-150 |
| 2.5 mmol/L | 16 | 30.7 ± 2.5 (4)-150 | −27.9%-150 |
| 5.0 mmol/L | 16 | 29.7 ± 4.8 (4)-150 | −30.3%-150 |
Percent ISCs formed during cyclic oxygenation/deoxygenation of DTT treated light density (45% Percoll layer) sickle cells at 37°C. Δ ISCs represents the percent change in the number of ISCs compared with ISCs on smears from 16 hours cycling in the absence of DTT. The values represent the mean and standard error from the number of experiments indicated in parentheses. The experiments were performed on four homozygous SS patients.
Indicates a significant difference from the 0.0 mmol/L concentration (P < .05).
Next, we wanted to test the efficacy of reducing agents, or antioxidants, which are in clinical use for other purposes. Cysteamine bitartrate converts cystines to cysteines and cysteine-cysteamine mixed disulfides. It has been approved by the Food and Drug Administration (FDA) for the treatment of nephropathic cystinosis and appears to maintain normal renal functions in patients receiving the drug.20 Cysteamine was ineffective in blocking ISC formation (at 1 to 50 mmol/L) and actually caused increases in the number of ISCs at higher concentrations (150 mmol/L and 200 mmol/L) (data not shown). Succimer (meso 2,3-dimercaptosuccinic acid) and dimercaprol are used clinically as chelators of heavy metals, such as lead.21 Succimer was ineffective at blocking ISC formation in vitro (at 1 to 30 mmol/L) and again caused increases in ISCs at concentrations of 100 to 200 mmol/L (data not shown). Dimercaprol caused a statistically significant decrease in ISCs at 10 μm concentration (−20.5%), but at higher concentrations (0.1 to 1.0 mmol/L) caused increases in percent ISCs (data not shown).
NAC is an antioxidant and is converted intracellularly to L-cysteine, which is a precursor to reduced glutathione. We felt that the combined activities of this drug might make it particularly efficacious in blocking ISC formation in vitro. As shown in Table 2, NAC caused statistically significant decreases in percent ISCs at concentrations of 250 μmol/L to 20 mmol/L NAC. At 20 mmol/L NAC, there was a reduction of 35.7% ISCs. NAC (20 mmol/L) had no effect on cell lysis during the 16 hours of cycling, as evidenced by identical concentrations of hemoglobin (measured by absorbance at 430 nm) in the incubation mixtures ± NAC (data not shown). Figure 1 shows a typical smear of ISCs formed in vitro in the presence (Fig 1C) or absence (Fig 1B) of 20 mmol/L NAC.
Effect of NAC on ISC Formation In Vitro
| [NAC] . | Time (h) . | % ISCs . | Δ ISCs % . |
|---|---|---|---|
| 0 mmol/L | 0 | 9.0 ± 3.6 (8)[7] | |
| 0 mmol/L | 16 | 59.0 ± 6.0 (8)[7] | |
| 0.1 mmol/L | 16 | 50.8 ± 15.1 (4)[4] | −14.0 |
| 0.25 mmol/L | 16 | 49.7 ± 11.5 (4)*[4] | −15.8* |
| 0.5 mmol/L | 16 | 49.8 ± 5.5 (8)*[7] | −15.6* |
| 10 mmol/L | 16 | 46.8 ± 2.9 (4)*[4] | −20.7* |
| 20 mmol/L | 16 | 38.0 ± 5.0 (4)*[4] | −35.7* |
| [NAC] . | Time (h) . | % ISCs . | Δ ISCs % . |
|---|---|---|---|
| 0 mmol/L | 0 | 9.0 ± 3.6 (8)[7] | |
| 0 mmol/L | 16 | 59.0 ± 6.0 (8)[7] | |
| 0.1 mmol/L | 16 | 50.8 ± 15.1 (4)[4] | −14.0 |
| 0.25 mmol/L | 16 | 49.7 ± 11.5 (4)*[4] | −15.8* |
| 0.5 mmol/L | 16 | 49.8 ± 5.5 (8)*[7] | −15.6* |
| 10 mmol/L | 16 | 46.8 ± 2.9 (4)*[4] | −20.7* |
| 20 mmol/L | 16 | 38.0 ± 5.0 (4)*[4] | −35.7* |
Percent ISCs formed during cyclic oxygenation/deoxygenation of low density (45% Percoll layer) sickle cells with various concentrations of NAC at 37°C. Δ ISCs represent the percent difference in the number of ISCs compared with ISCs on smears from 16 hours cycling in the absence of NAC. The values represent the mean and standard error from the number of experiments indicated in parentheses. Number of individual patients is shown in square brackets.
Indicates a singificant difference from the 0 mmol/L concentration (P < .05).
To test whether NAC might affect SS erythrocyte dehydration, we isolated light density SS RBCs and incubated them at 37°C under cyclic deoxygenation-reoxygenation for 16 hours plus (Fig 2C) or minus (Fig 2B) 20 mmol/L NAC. The control represents LDSS erythrocytes, which were incubated at 37°C for 16 hours minus NAC and without cycling (Fig2A). As shown in Fig 2 and Table 3, in vitro cycling of LDSS erythrocytes causes a large conversion to high density SS erythrocytes. NAC (20 mmol/L) partially blocks this conversion causing statistically significant decreases in the percent RBCs found in the 60% Percoll layer (density = 1.112 g/mL) and increases in the percent RBCs found at lower density (45% and 50% Percoll layers, density = 1.093 and 1.100 g/mL) (Table 3). There was no statistically significant difference in the percent ISCs found at any Percoll layer ± 20 mmol/L NAC. This means that decreases in ISCs found in whole blood smears from NAC-treated cycled cells (Table 2) was accompanied by NAC blocking the formation of high density SS cells in vitro (Table 3), which contain the highest percent ISCs.
Effect of NAC on SS erythrocyte density. Low density SS erythrocytes that were incubated at 37°C for 16 hours without cycling or NAC (A), with cycling, but without NAC (B), and with cycling in the presence of 20 mmol/L NAC (C), were placed on Percoll gradients (45% to 65%) and centrifuged at 907g for 45 minutes. Note NAC's ability to inhibit dense cell formation. Density of the RBCs in different Percoll layers was obtained by sedimenting density marker beads (Pharmacia, Piscataway, NJ) under identical conditions.
Effect of NAC on SS erythrocyte density. Low density SS erythrocytes that were incubated at 37°C for 16 hours without cycling or NAC (A), with cycling, but without NAC (B), and with cycling in the presence of 20 mmol/L NAC (C), were placed on Percoll gradients (45% to 65%) and centrifuged at 907g for 45 minutes. Note NAC's ability to inhibit dense cell formation. Density of the RBCs in different Percoll layers was obtained by sedimenting density marker beads (Pharmacia, Piscataway, NJ) under identical conditions.
Effect of NAC on Dense Cell Formation
| . | 45% Percoll . | 50% Percoll . | 55% Percoll . | 60% Percoll . | 65% Percoll . |
|---|---|---|---|---|---|
| Control | |||||
| RBC total ×107 | 52.8 ± 22.5 | 20.9 ± 3.5 | 15.8 ± 3.4 | 1.0 ± 0.5 | 0.3 ± 0.2 |
| % RBC | 52.2 ± 11.3 | 28.3 ± 11.2 | 18.4 ± 2.8 | 0.8 ± 0.4 | 0.3 ± 0.2 |
| % ISCs | 9.7 ± 1.4 | 11.5 ± 4.8 | 13.7 ± 0.7 | 16.4 ± 8.9 | 19.7 ± 12.4 |
| 0 mmol/L NAC | |||||
| RBC total ×107 | 12.3 ± 5.5 | 6.4 ± 1.3 | 32.2 ± 7.2 | 33.4 ± 14.0 | 11.6 ± 8.4 |
| % RBC | 11.1 ± 3.2 | 8.7 ± 2.7 | 41.1 ± 10.4 | 30.6 ± 6.7 | 8.6 ± 5.8 |
| % ISCs | 23.0 ± 3.2 | 35.9 ± 4.0 | 39.9 ± 3.0 | 45.6 ± 2.9 | 35.5 ± 12.3 |
| 20 mmol/L NAC | |||||
| RBC total ×107 | 17.3 ± 4.9 | 13.2 ± 3.8 | 32.1 ± 6.0 | 25.0 ± 14.4 | 3.7 ± 2.9 |
| % RBC | 18.6 ± 4.0* | 15.7 ± 2.9* | 42.7 ± 9.5 | 20.4 ± 8.2* | 2.7 ± 1.8 |
| % ISCs | 26.3 ± 7.8 | 35.6 ± 10.9 | 54.7 ± 5.7 | 46.5 ± 3.9 | 33.3 ± 11.9 |
| . | 45% Percoll . | 50% Percoll . | 55% Percoll . | 60% Percoll . | 65% Percoll . |
|---|---|---|---|---|---|
| Control | |||||
| RBC total ×107 | 52.8 ± 22.5 | 20.9 ± 3.5 | 15.8 ± 3.4 | 1.0 ± 0.5 | 0.3 ± 0.2 |
| % RBC | 52.2 ± 11.3 | 28.3 ± 11.2 | 18.4 ± 2.8 | 0.8 ± 0.4 | 0.3 ± 0.2 |
| % ISCs | 9.7 ± 1.4 | 11.5 ± 4.8 | 13.7 ± 0.7 | 16.4 ± 8.9 | 19.7 ± 12.4 |
| 0 mmol/L NAC | |||||
| RBC total ×107 | 12.3 ± 5.5 | 6.4 ± 1.3 | 32.2 ± 7.2 | 33.4 ± 14.0 | 11.6 ± 8.4 |
| % RBC | 11.1 ± 3.2 | 8.7 ± 2.7 | 41.1 ± 10.4 | 30.6 ± 6.7 | 8.6 ± 5.8 |
| % ISCs | 23.0 ± 3.2 | 35.9 ± 4.0 | 39.9 ± 3.0 | 45.6 ± 2.9 | 35.5 ± 12.3 |
| 20 mmol/L NAC | |||||
| RBC total ×107 | 17.3 ± 4.9 | 13.2 ± 3.8 | 32.1 ± 6.0 | 25.0 ± 14.4 | 3.7 ± 2.9 |
| % RBC | 18.6 ± 4.0* | 15.7 ± 2.9* | 42.7 ± 9.5 | 20.4 ± 8.2* | 2.7 ± 1.8 |
| % ISCs | 26.3 ± 7.8 | 35.6 ± 10.9 | 54.7 ± 5.7 | 46.5 ± 3.9 | 33.3 ± 11.9 |
RBC total and percent ISCs formed were calculated after density separation via Percoll gradients of SS RBCs, which underwent cyclic oxygenation/deoxygenation of low density (45% Percoll layer) sickle cells with various concentrations of NAC at 37°C for 16 hours. The control represents the sickle cells without cycling and without NAC treatment, but that were kept at 37°C and shaken for 16 hours. All values (except control where n = 3) represent mean and standard error of four experiments (n = 4 [different patients]).
Indicates a significant difference from the 0.0 mmol/L concentration (P < 0.05).
We have previously shown that light density ISCs, formed by in vitro cycling in the presence of NO3−, demonstrate slow dissociation of the spectrin membrane skeleton.22 This result uncoupled the ISC membrane skeleton defect from the hydration status of the SS erythrocyte. Therefore, we wanted to ask whether NAC might also be having a direct effect on SS erythrocyte β-actin. To determine whether β-actin thiols might be one target of NAC, we repeated the NAC experiments with larger amounts of light density SS RBCs as our starting material (300 mL of a 2% RBC solution). This allowed us sufficient material to count the number of ISCs after 16 hours of cycling, as well as measure the number of β-actin thiols with DTNB.11 In four independent experiments, we found that 20 mmol/L NAC caused a statistically significant decrease of 32.8% ± 5.7% ISCs as compared with samples that were cycled in the absence of NAC. There was an inverse trend showing increases in β-actin thiols in the presence of 20 mmol/L NAC. These same 20 mmol/L NAC samples were found to have a statistically significant increase of 23.1% ± 8.2% available β-actin thiols (Table 4). The available thiols were increased from 1.3 ± 0.1 in the absence of NAC to 1.6 ± 0.2 in the presence of 20 mmol/L NAC. An increase of 0.3 thiols is consistent with Δ ISCs being 32.8%. We concluded that NAC does effect the number of available thiols in sickle cell β-actin. The lack of correlation, from experiment to experiment, in the magnitude of ISC reduction and β-actin thiol increase could be taken to mean that actin thiol status and ISC morphology are mechanistically unrelated. But this is not a likely explanation given our previously published results.11-15 A more likely explanation for the lack of correlation is the small number of experiments along with high patient-to-patient variability.
Effect of NAC on In Vitro Formation of ISCs and β-Actin Thiols
| Experiment No. . | Δ ISCs % . | Δ Actin Thiols % . |
|---|---|---|
| 1 | −29.9 | +46.5 |
| 2 | −18.4 | +22.4 |
| 3 | −37.5 | +12.0 |
| 4 | −45.2 | +11.7 |
| Mean | −32.8 ± 5.73-150 | +23.1 ± 8.23-150 |
| Experiment No. . | Δ ISCs % . | Δ Actin Thiols % . |
|---|---|---|
| 1 | −29.9 | +46.5 |
| 2 | −18.4 | +22.4 |
| 3 | −37.5 | +12.0 |
| 4 | −45.2 | +11.7 |
| Mean | −32.8 ± 5.73-150 | +23.1 ± 8.23-150 |
The data represent the change in ISCs and β-actin available thiols in sickle cells which have been oxygenation-deoxygenation cycled for 16 hours in the presence of 0 or 20 mmol/L, NAC. Mean values are given ± standard error. The four experiments represent four independent homozygous SS subjects.
Indicates a significant difference (P < .05).
It was clear that NAC had the ability to block the formation of dense cells and ISCs in vitro and that it had at least two targets: channels involved in cell dehydration and membrane skeletal β-actin. We next wanted to test whether NAC could convert ISCs back to biconcave cells. To answer this question, we isolated dense cells from six independent homozygous SS subjects. In six separate experiments, with six different sickle cell patients, the dense cell population contained a mean of 61.2% ± 5.1% de novo ISCs. Dense cells obtained from the 65% Percoll layer were incubated for 16 hours at 37°C in our incubation buffer ± 20 mmol/L NAC. Those dense cells incubated in the absence of NAC contained 49.7% ± 4.9% ISCs indicating that the incubation buffer alone can cause a significant reduction in ISCs during a 16-hour incubation at 37°C. Those incubated with 20 mmol/L NAC contained 42.2% ± 3.8% ISCs, which represented a statistically significant mean percent difference of 14.0% ± 4.1% (P < .05). Therefore, NAC has the ability to convert de novo ISCs back to the biconcave shape.
Due to the increased deposits of heme and free iron on the cytoplasmic surface of the high density SS erythrocyte membrane and the resultant formation of superoxide, peroxides, and hydroxyl radicals,6,23,24 we have proposed that the diminished levels of GSH in these same dense cells25,26 is critical to oxidative damage to β-actin and other target proteins.15We further proposed that this oxidative damage to β-actin, and other targets, leads to the formation of dense cells and ISCs. To test this hypothesis, we incubated low density sickle cells at 4°C in the presence and absence of 1.0 mmol/L CDNB. CDNB lowers GSH levels within erythrocytes by forming an irreversible adduct, 2,4-dinitrophenol-S-glutathione.27 As shown in the kinetic experiments presented in Fig 3, there is a rapid decrease in GSH levels even after 1 hour of incubation with CDNB, reaching a 90% decrease after 24 hours. The percentage of high density cells (those found in the 60% and 65% Percoll layers) increases constantly at 1 hour, 12 hours, and 24 hours CDNB treatment. Therefore, diminishing GSH levels in CDNB-treated cells is sufficient to cause cellular dehydration.
Diminishment of GSH leads to formation of dense cells. Percent of high density cells (% HDSS) formed were calculated and plotted after density separation via Percoll gradients of SS RBCs, which underwent incubation at 4°C of low density (45% Percoll layer) sickle cells without (−□−□−) or with (−▪−▪−) 1 mmol/L CDNB. Mol concentrations of GSH were determined in the same RBCs in the absence (−○−○−) and in the presence (−•−•−) of 1 mmol/L CDNB. Data is presented as mean ± standard error of four independent experiments. Values for GSH and HDSS were statistically significant (P < .05) at 1 hour, 12 hours, and 24 hours when comparing ± CDNB samples.
Diminishment of GSH leads to formation of dense cells. Percent of high density cells (% HDSS) formed were calculated and plotted after density separation via Percoll gradients of SS RBCs, which underwent incubation at 4°C of low density (45% Percoll layer) sickle cells without (−□−□−) or with (−▪−▪−) 1 mmol/L CDNB. Mol concentrations of GSH were determined in the same RBCs in the absence (−○−○−) and in the presence (−•−•−) of 1 mmol/L CDNB. Data is presented as mean ± standard error of four independent experiments. Values for GSH and HDSS were statistically significant (P < .05) at 1 hour, 12 hours, and 24 hours when comparing ± CDNB samples.
DISCUSSION
Hebbel et al23 have shown that sickle cells generate about twice the amount of activated oxygen species found in control RBCs. The reason for this increase in oxygen radicals is the result of accelerated autoxidation of HbS to methemoglobin, a conversion that causes release of heme.6 Heme is increased in content on the cytoplasmic surface of sickle cell membranes and this correlates with membrane thiol modification.24 The amount of heme and free iron associated with the cytoplasmic surface of the SS erythrocyte membrane is particularly increased in the most dense fractions of SS RBCs.6 Reduced glutathione levels are diminished by about 20% in SS RBCs as compared with high reticulocyte controls and is lower in high density SS erythrocytes compared with low density SS erythrocytes.25,26 The diminished levels of reduced glutathione are related to decreased glutathione reductase activity, increased glutathione peroxidase activity, and inhibition of the pentose phosphate shunt in SS erythrocytes.25 Therefore, sickle cells have increased activated oxygen species, and dense cells also have diminished levels of GSH to protect against oxidative damage. This combination is probably responsible for oxidation of thiol groups in many target proteins.
In this study, we show that an antioxidant, NAC, can block dense cell formation in vitro. Dense cell formation is caused by water loss from sickle cells, in response to K+ leakage. The cation transport systems that appear to be involved in dehydration of SS erythrocytes are the K+-Cl−cotransporter, the Ca2+-activated K+ channel, and the deoxygenation-induced Na+, K+, and Ca2+ leak pathways.8 Therefore, these are the most likely targets of NAC protection of oxidative damage leading to decreased dense cell formation. Because the dense cells contain the highest percent ISCs, this supplies a partial explanation of NAC's effect on ISC formation. But it does not get directly at the molecular mechanism of NAC's effect on ISC formation. Dense cells have decreased fetal hemoglobin and increased hemoglobin S concentration leading to greater polymerization of HbS.6,7 This would cause many of the high density SS erythrocytes to become sickled in shape. But what causes the cell to lock into an irreversibly sickled shape? This cannot be explained by dehydration alone for several reasons. First, some ISCs in blood from SS subjects are low density cells.6-8Furthermore, we have shown that substitution of NO3− for Cl− in the in vitro deoxygenation-reoxygenation cycling experiments results in a high concentration of low density ISCs.22 These low density ISCs show slow dissociation of their membrane skeleton at 37°C.22 Therefore, the formation of ISCs can be uncoupled from cellular dehydration of SS erythrocytes. While dense cell fractions contain many sickled cells, we believe that the locking of the ISC requires a modification in the membrane skeleton.15
The C284-C373 disulfide bridge in β-actin is the key determinant of the slow dissociation of the ISC membrane skeletal components and therefore the inability of the ISC to remodel its shape.11-15 We therefore proposed that reducing agents and antioxidants might be effective in blocking ISC formation in vitro. Of the clinically relevant antioxidants that we have tested, NAC was the most efficacious in inhibiting ISC formation in vitro. Furthermore, the NAC-linked reduction in ISCs was accompanied by an increase in β-actin thiols. Therefore, in this study we have identified two possible targets for NACs blockage of dense cell and ISC formation: channels involved in K+ leakage and β-actin.
NAC, as the N-acetyl derivative of L-cysteine, is an antioxidant.28 It is highly permeable to cell membranes, and within the cytoplasm, is converted to L-cysteine, which is a precursor to GSH.29 It, therefore, could protect thiols from oxidative damage both by its antioxidant capacity, as well as raising the levels of GSH. Indeed, adult respiratory distress syndrome (ARDS) patients treated with NAC (70 mg/kg) show a 30% increase in erythrocyte glutathione in 1 day and a 47% increase after 4 days with drug administered every 8 hours.30 In this regard, our experiments showing that lowering GSH levels (with CDNB) can lead to dense cell formation are of substantial interest. In the future, we must determine whether replenishment of GSH with NAC can reverse the effect of CDNB on dense cell formation in vitro.
ACKNOWLEDGMENT
The authors thank Kathy Billingsley and Ashley W. Turbeville for manuscript preparation.
Supported by Grant No. 3P60 HL38639 from the National Institutes of Health, Bethesda, MD, to the USA Comprehensive Sickle Cell Center. S.R.G. serves as Principal Investigator and Program Director.
Address reprint requests to Steven R. Goodman, PhD, Professor and Chairman, Department of Structural and Cellular Biology, University of South Alabama College of Medicine, MSB 2042, Mobile, AL 36688.
The publication costs of this article were defrayed in part by page charge payment. This article must therefore be hereby marked "advertisement" is accordance with 18 U.S.C. section 1734 solely to indicate this fact.

This feature is available to Subscribers Only
Sign In or Create an Account Close Modal